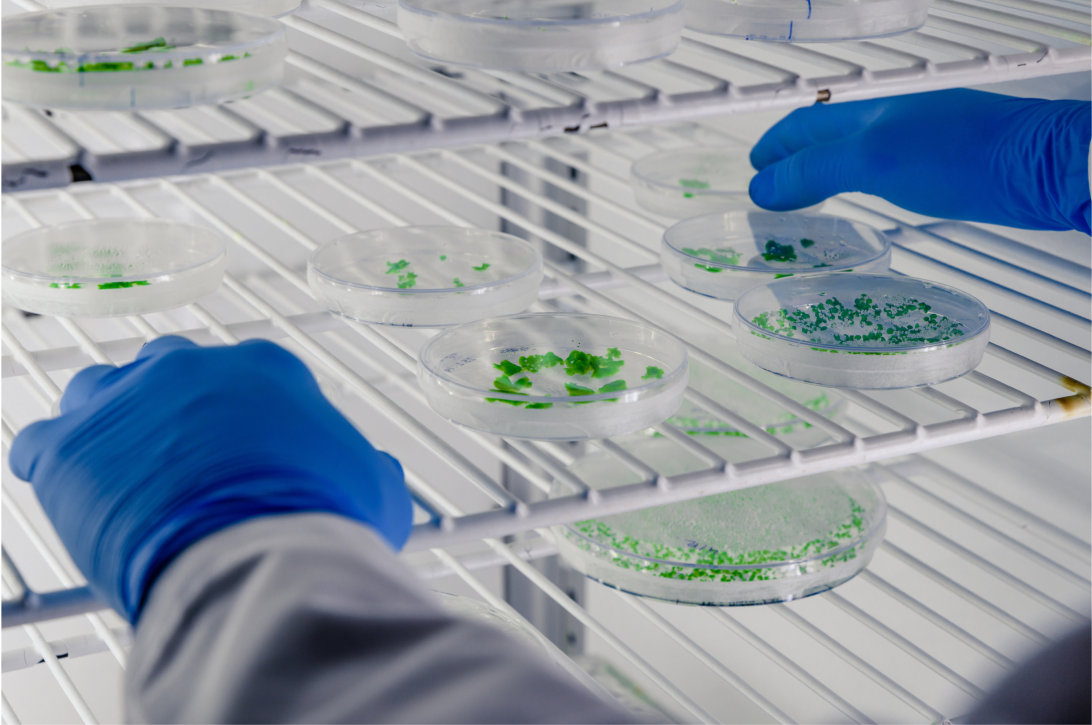

Tempo de Leitura: Aproximadamente 14 minutos
Categoria: Aquisição de Reagentes Químicos
Introdução
Navegar pelo vasto oceano de opções quando se trata de fornecedores de reagentes químicos pode ser uma tarefa desafiadora. Encontrar parceiros confiáveis é essencial para o sucesso de qualquer laboratório ou indústria que dependa desses insumos vitais. Neste guia completo, abordaremos os principais aspectos a considerar ao escolher fornecedores de reagentes, garantindo que suas necessidades de suprimentos químicos sejam atendidas com qualidade, segurança e eficiência.
Importância dos Reagentes
Os Reagentes como Elemento Vital
Os reagentes químicos desempenham um papel crucial em inúmeras aplicações, desde pesquisa científica até a fabricação industrial. Ter acesso a reagentes de alta qualidade é fundamental para garantir a precisão e confiabilidade de processos e resultados.
Impacto na Qualidade dos Resultados
A qualidade dos reagentes utilizados tem um impacto significativo na qualidade dos resultados obtidos. Escolher o fornecedor adequado é uma decisão crítica que pode afetar diretamente a credibilidade de seus experimentos e processos.
Identificando Suas Necessidades
Compreenda Sua Aplicação
Antes de escolher um fornecedor, é essencial compreender suas necessidades específicas. Cada aplicação, seja ela na pesquisa, controle de qualidade, produção ou qualquer outra área, pode exigir reagentes diferentes. Portanto, identifique claramente o que você precisa antes de prosseguir.
Quantidade e Regularidade
Avalie a quantidade de reagentes necessária e com que regularidade você precisará deles. Isso influenciará sua escolha de fornecedor, especialmente se você precisa de um abastecimento regular e confiável.
Qualidade e Conformidade
Certificações e Padrões
Verifique se o fornecedor segue as normas de qualidade relevantes. Isso pode incluir certificações como ISO ou Boas Práticas de Fabricação (GMP), dependendo da área em que você atua. A conformidade com padrões reconhecidos é um indicador sólido de qualidade.
Rastreabilidade
A capacidade de rastrear a origem e o histórico de um reagente é essencial para garantir sua autenticidade e qualidade. Certifique-se de que o fornecedor ofereça informações detalhadas sobre a procedência de seus produtos.
Reputação e Avaliações
Pesquisa de Mercado
Realize uma pesquisa de mercado para avaliar a reputação do fornecedor. Consulte outras empresas, laboratórios ou instituições que tenham experiência com o mesmo fornecedor. As referências podem fornecer informações valiosas sobre a confiabilidade e qualidade dos produtos.
Avaliações Online
Verifique as avaliações e feedbacks online de outros clientes que tenham feito negócios com o fornecedor. Plataformas de revisão, fóruns de discussão e redes sociais são fontes valiosas para obter informações sobre a satisfação dos clientes.
Suporte Técnico
Disponibilidade de Suporte
Certifique-se de que o fornecedor ofereça suporte técnico. Ter especialistas à disposição para responder a perguntas ou resolver problemas é inestimável, especialmente quando se lida com reagentes complexos ou aplicações críticas.
Assistência em Caso de Problemas
Avalie como o fornecedor lida com problemas, como entregas atrasadas, reagentes com defeito ou outros contratempos. Ter um plano de contingência eficaz é fundamental para evitar interrupções prejudiciais.
Logística e Entrega
Prazos de Entrega
Verifique os prazos de entrega propostos pelo fornecedor. Isso é crucial para garantir que você receba seus reagentes quando precisar deles. Atrasos na entrega podem ter sérias consequências, principalmente em aplicações críticas.
Condições de Armazenamento
Certifique-se de que o fornecedor segue procedimentos adequados de armazenamento e transporte para evitar a degradação dos reagentes. Manter a integridade dos produtos durante o transporte é essencial para a qualidade final.
Conclusão
A escolha de fornecedores de reagentes confiáveis é um passo crítico para garantir o sucesso de suas operações. Compreender suas necessidades, verificar a qualidade, reputação e suporte do fornecedor, e prestar atenção à logística e à entrega são fatores essenciais a serem considerados. Tomar decisões informadas ao escolher fornecedores de reagentes pode ter um impacto significativo na qualidade de seus processos e resultados. Portanto, não subestime a importância de realizar uma pesquisa cuidadosa e fazer parcerias estratégicas com fornecedores confiáveis.